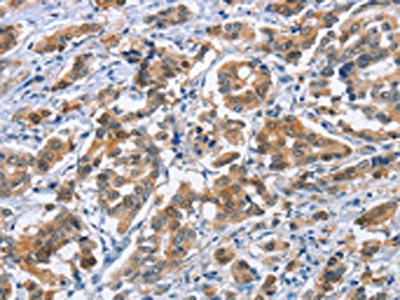
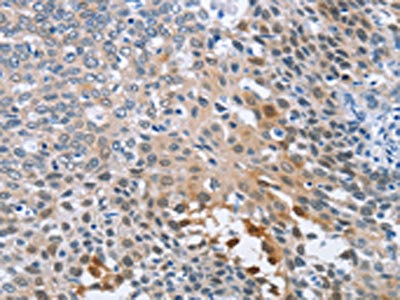

CRABP2 Antibody
-
中文名稱:CRABP2兔多克隆抗體
-
貨號:CSB-PA168224
-
規格:¥1100
-
圖片:
-
The image on the left is immunohistochemistry of paraffin-embedded Human breast cancer tissue using CSB-PA168224(CRABP2 Antibody) at dilution 1/20, on the right is treated with fusion protein. (Original magnification: ×200)
-
The image on the left is immunohistochemistry of paraffin-embedded Human cervical cancer tissue using CSB-PA168224(CRABP2 Antibody) at dilution 1/20, on the right is treated with fusion protein. (Original magnification: ×200)
-
-
其他:
產品詳情
-
Uniprot No.:
-
基因名:CRABP2
-
別名:Cellular retinoic acid binding protein 2 antibody; Cellular retinoic acid binding protein II antibody; Cellular retinoic acid-binding protein 2 antibody; Cellular retinoic acid-binding protein II antibody; CRABP II antibody; CRABP-II antibody; Crabp2 antibody; CRABPII antibody; RABP2_HUMAN antibody; RBP6 antibody; Rretinoic acid-binding protein, cellular, type II antibody
-
宿主:Rabbit
-
反應種屬:Human,Mouse,Rat
-
免疫原:Fusion protein of Human CRABP2
-
免疫原種屬:Homo sapiens (Human)
-
標記方式:Non-conjugated
-
抗體亞型:IgG
-
純化方式:Antigen affinity purification
-
濃度:It differs from different batches. Please contact us to confirm it.
-
保存緩沖液:-20°C, pH7.4 PBS, 0.05% NaN3, 40% Glycerol
-
產品提供形式:Liquid
-
應用范圍:ELISA,IHC
-
推薦稀釋比:
Application Recommended Dilution ELISA 1:1000-1:2000 IHC 1:25-1:100 -
Protocols:
-
儲存條件:Upon receipt, store at -20°C or -80°C. Avoid repeated freeze.
-
貨期:Basically, we can dispatch the products out in 1-3 working days after receiving your orders. Delivery time maybe differs from different purchasing way or location, please kindly consult your local distributors for specific delivery time.
-
用途:For Research Use Only. Not for use in diagnostic or therapeutic procedures.
相關產品
靶點詳情
-
功能:Transports retinoic acid to the nucleus. Regulates the access of retinoic acid to the nuclear retinoic acid receptors.
-
基因功能參考文獻:
- Semiquantitative and quantitative analyses of the markers RARA and CRABP2 indicate their potential as biomarkers for tumor progression and their participation in nephroblastoma tumorigenesis PMID: 29378601
- These data suggest a retinoic acid-independent, non-tumor suppressor role of CRABP2 for the survival of Malignant peripheral nerve sheath tumor (MPNST) cells in vitro. Targeting CRABP2 overexpression may represent a unique approach for the treatment of human MPNST. PMID: 28502478
- A high expression ratio between FABP5 and CRABPII may be related to CP tumor recurrence and ATRA could be a potential therapeutic agent for CP chemotherapy. PMID: 27418530
- reducing CRABP2 levels may enhance the therapeutic index of Retinoic acid in glioblastoma multiforme patients PMID: 26893190
- in esophageal squamous carcinogenesis by significantly inhibiting cell growth, inducing cell apoptosis and blocking cell metastasis both in vitro and in vivo PMID: 26839961
- The anticarcinogenic activities of CRABP2 are mediated by both HuR and RAR. PMID: 25320093
- CBX3 and CRABP2 expression was markedly increased in lung cancer tissues PMID: 24751108
- Reengineering of cellular retinoic acid binding protein II (CRABPII) to be capable of binding retinal as a protonated Schiff base is described PMID: 24059243
- CRABP2 controls mRNA stabilization by HuR. PMID: 24687854
- overexpression of CRABP-II is a late event of pancreatic carcinogenesis, and it could be used as a diagnostic marker PMID: 24709110
- all three proteins (RDH10, RALDH2, and CRABP2) appeared to be required for ATRA production induced by activation of PPARgamma PMID: 23833249
- E-FABP showed high exp ression in NSCLC, and the increased E-FABP expression may involved in the occurrence and development of NSCLC PMID: 23327868
- Hypermethylation in the CpG island of the CRABP2 gene is associated with astrocytic gliomas. PMID: 22275178
- Aberrant methylation in CRABP-II reduces the expression of CRABP-II that in turn confers retinoic acid resistance in medulloblastoma cells. PMID: 22153617
- Low CRABP2 is associated with pancreatic ductal adenocarcinoma. PMID: 22010213
- Nuclear translocation of cellular retinoic acid-binding protein II is regulated by retinoic acid-controlled SUMOylation PMID: 21998312
- Trophoblast spheroids cocultured with endometrial cells overexpressing CRABP2 are defective in expansion and exhibit apoptosis, suggesting that CRABP2 is involved in abnormal endometrium-trophoblast interaction, leading to implantation failure. PMID: 21605859
- Data show that NIPER-4 induces cIAP1-mediated ubiquitylation of CRABP-II, resulting in the proteasomal degradation. PMID: 21414315
- Individual variation in ALDH1A2/CRABP2 genes may account for subtle variations in retinoic acid-dependent human embryogenesis. PMID: 20308937
- Data sghow a higher frequency of CRABP2 and MX1 hypermethylation in primary HNSCC when compared with lymphocytes from healthy individuals. PMID: 20019841
- Direct channeling of retinoic acid between cellular retinoic acid-binding protein II and retinoic acid receptor sensitizes mammary carcinoma cells to retinoic acid-induced growth arrest. PMID: 11909957
- Cyclin D3 is a cofactor of retinoic acid receptors, modulating their activity in the presence of this protein PMID: 12482873
- In this study, we excluded mutations within the complete coding region and the promoter of LMNA and the CRABP II gene in HIV-1 infected patients with lipodystrophy PMID: 12844477
- CRABP-II has a role in wound re-epithelialisation by dermal fibroblasts PMID: 14766225
- Phosphorylation/dephosphorylation of retinoic x receptor alpha via protein kinase C may be involved in the regulation of CRABP-II gene expression. PMID: 15225641
- Data suggest that the ligand-controlled nuclear localization signal of CRABP-II may represent a general mechanism for posttranslational regulation of the subcellular distribution of a protein. PMID: 15866176
- Transient transfection of either all-trans-retinoic acid (ATRA) receptor alpha or estrogen receptor alpha expression vectors increased CRABPII expression in MDA-MB-231 cells PMID: 15870697
- CRABP-II overexpression in CAKI-2 RCC cells did not significantly influence RA associated antiproliferative actions. PMID: 16215318
- MycN binds to the promoter of CRABP-II and induces CRABP-II transcription directly in neuroblastoma. PMID: 16912187
- Results describe the structure of apo-wild type (WT) CRABPII at 1.35 A and show that apo- and holo-CRABPII share very similar structures. PMID: 16979656
- AP2 factors regulate CRABPII expression in human mammary epithelial cells and breast cancer cells PMID: 17187826
- results show that the CRABP2 gene is associated with increased plasma LDL-C concentrations. Carriers of the C allele had significantly higher LDL-C in healthy males, HIV-infected patients, and patients with familial hypercholesterolemia PMID: 17484622
- Retinoic acid and retinol regulate expression of cellular retinol binding protein 1 and cellular RA binding protein 2 in fibroid and myometrial cells. PMID: 18343808
- MycN and DNA methylation are responsible for CRABP-II expression in pediatric tumors and demethylation of CRABP-II may be an early event in tumor development. PMID: 18955045
- Derangement/lack of a critical factor necessary for RARalpha function induces epigenetic repression of a RA-regulated gene network downstream of RARalpha, with major pleiotropic biological outcomes. PMID: 19173001
顯示更多
收起更多
-
亞細胞定位:Cytoplasm. Endoplasmic reticulum. Nucleus. Note=Upon ligand binding, a conformation change exposes a nuclear localization motif and the protein is transported into the nucleus.
-
蛋白家族:Calycin superfamily, Fatty-acid binding protein (FABP) family
-
數據庫鏈接:
Most popular with customers
-
-
YWHAB Recombinant Monoclonal Antibody
Applications: ELISA, WB, IHC, IF, FC
Species Reactivity: Human, Mouse, Rat
-
Phospho-YAP1 (S127) Recombinant Monoclonal Antibody
Applications: ELISA, WB, IHC
Species Reactivity: Human
-
-
-
-
-